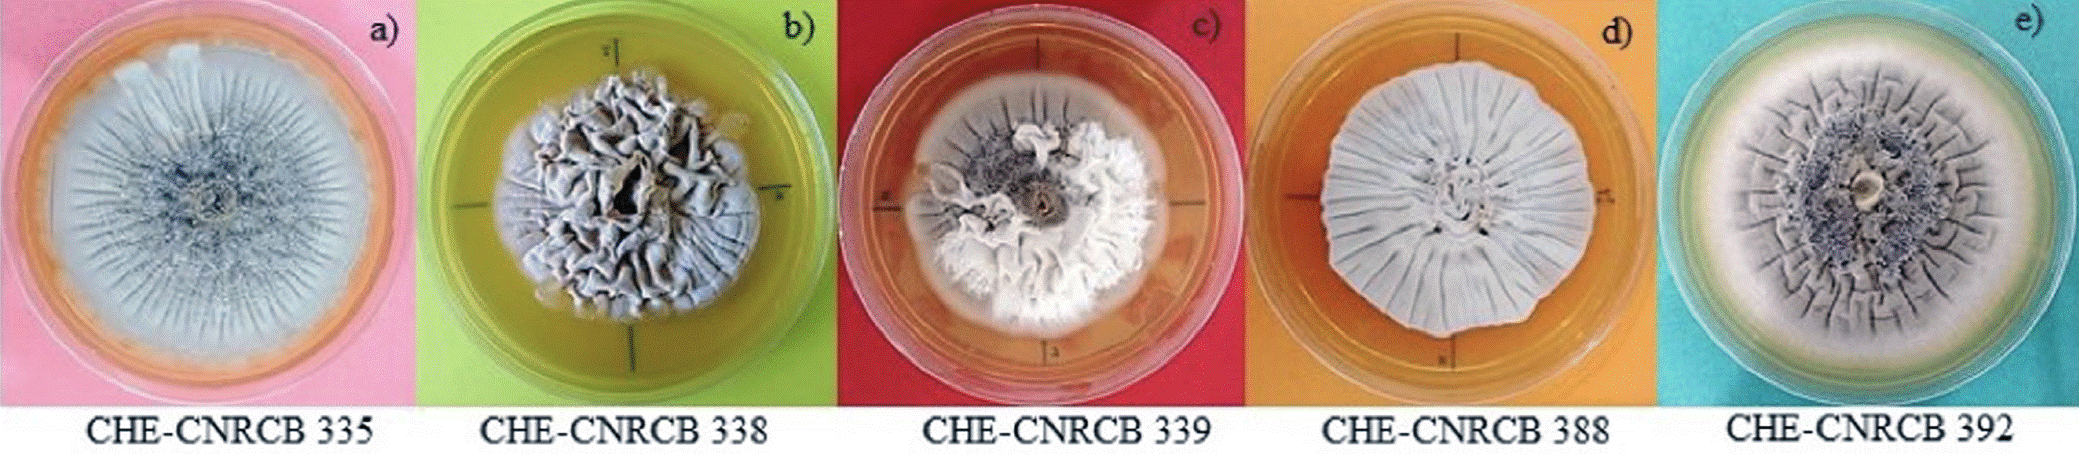
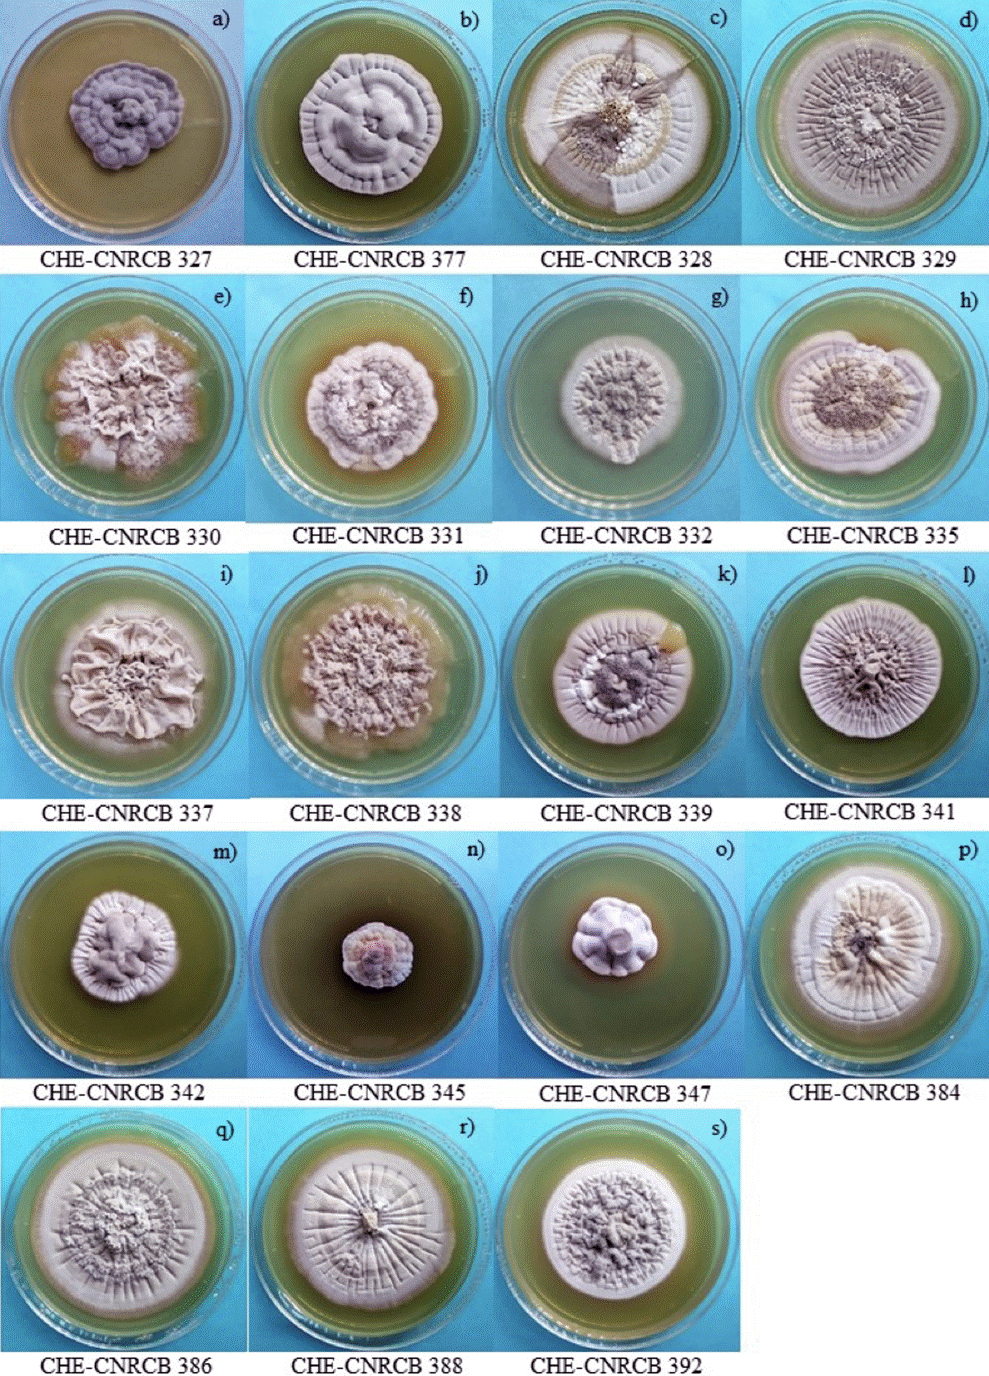

Introduction
All research or applied studies that involve the use of living microorganisms require a constant supply of them in optimal conditions (Humber 2012). The study, management, and utilization of microscopic fungi require the use of proper conservation techniques (Mier et al. 2005). In some cases, the process of identifying taxonomic fungal species may take a long time and can affect the viability of strains. Therefore, it is crucial to preserve them for later identification (Kannojia et al. 2020, Smith et al. 2001). Furthermore, certain isolates have unique characteristics that are of practical value for medical or biotechnological applications, such as producing enzymes, proteins, bioactive compounds, antibiotics, or biopolymers (Prakash et al. 2013, Sievers 2015, Kannojia et al. 2020). Methods that employ low temperatures, such as lyophilization, ultracold-freezing at -70 °C, and cryopreservation at -196 °C, generally provide optimal conservation for most species of fungi. However, there are exceptions where the choice of a method poses certain limitations, either due to the microorganism’s sensitivity to the method or its slow growth (Mier et al. 2005, Humber 2012). Fortunately, alternative conservation methods are available. One of these methods is preservation with mineral oil (MO) or paraffinic oil, which is a simple and accessible technique for conserving both sporulating and non-sporulating fungi, regardless of laboratory size or infrastructure (Kannojia et al. 2020). This economical and effective procedure was first used by Lumière and Chevrotier (1914), and later by Buell and Weston (1947), and is still in use today. The mechanism of this preservation method involves the prevention of dehydration, leading to a reduction in metabolic activity and growth (Smith and Onios 1994, Singh et al. 2018, Kannojia et al. 2020). The primary advantage of this technique is its ability to maintain the viability of certain fungal species for extended periods. Additionally, this method enables the preservation of species that are intolerant to other preservation methods, including low-temperature techniques, while also preventing mites contamination, without the requirement of specialized equipment (Smith and Onios 1994). However, the drawbacks of this method include the possibility of contamination by fungi that generate airborne spores (such as Aspergillus and/or Penicillium), slow growth of recovered strains, and alterations in pathogenicity and/or virulence after decades of storage (Smith and Onios 1994, Mier et al. 2005).
The Colección de Hongos Entomopatógenos of the Servicio Nacional de Sanidad, Inocuidad y Calidad Agroalimentaria (SENASICA), in conjunction with the Dirección General de Sanidad Vegetal (DGSV) of the Government of Mexico, implements biological control programs to manage various pests using entomopathogenic fungi (EPF). Among the prominent genera is Hirsutella, a group of asexually reproducing fungi in the Ophiocordycipitaceae family, originally described by mycologist Narcisse Théophile Patouillard in 1892. The genus includes over 70 species, some of which are pathogens of insects, mites, and nematodes, making them suitable as microbial agents for biological control (Sung et al. 2007). One particularly useful species is Hirsutella citriformis Speare, which is naturally abundant and plays an important role in the control and/or reduction of pests in citrus crops (Raymundo-Jiménez et al. 2019). Field observations have shown a 23 % infection rate by the fungus in adult Asian citrus psyllids, Diaphorina citri Kuwayama, perched on leaves. However, its laboratory conservation presents some challenges due to its slow growth and limited conidial production (Raymundo-Jiménez et al. 2019), as well as its susceptibility to preservation methods such as freeze-drying or limited viability in sterile distilled water (less than 6 months) (Ayala-Zermeño et al. 2017). This study aims to evaluate MO as a method of prolonged conservation for 20 isolates of Hirsutella spp.
Materials and methods
Fungi
The multi-spore isolates of H. citriformis and Hirsutella thompsonii Fisher (Hypocreales: Ophiocordycipitaceae) used in this study are part of the Colección de Hongos Entomopatógenos (CHE) at the Departamento de Control Biológico (DCB), an institutional partner of the World Data Centre for Microorganisms (WDCM), with registration number 1034/CHE-CNRCB (Table 1). The isolates used in this study CHE-CNRCB 328, 329, 330, 331, 332, 333, 335, 337, 338, 339, 341, 342, 345, and 347 of H. citriformis were previously characterized (Berlanga-Padilla et al. 2018), in another research, Pérez-González et al. (2015a, 2015b) characterized the isolate 392 (IB-Hir-2), the rest of the strains used 384, 386, and 388 have been studied and morphologically characterized in the CHE (unpublished results by Berlanga-Padilla A. 2022, Com. Pers.). In this study, two strains of H. thompsonii, 327 and 377, were also evaluated for comparison with strains of H. citriformis. Although these strains belong to the same genus, they have different growth and sporulation characteristics, which makes them resistant to drying and freezing conditions and tolerate preservation in techniques such as freeze-drying (lyophilization) and silica gel, which are not conducive to H. citriformis.
Table 1 Characteristics of isolates of Hirsutella spp.
| Acronyms | Host | Host culture | Locality |
|---|---|---|---|
| Hirsutella thompsonii | |||
| 327 | Aceria guerreronis | Coconut tree | Cuba |
| [Aracnidae: Acari: Eriophyidae] | 23°0’47.282’’ N 80°49’58.349’’ W | ||
| 377 | Citrus rust mite | Orange | El Galage, Ixtlahuacan, Colima, México. |
| [Phylocoptruta oleivora] | 19° 0’ 4.284’’ N 103° 44’ 10.967’’ W | ||
| Hirsutella citriformis | |||
| 328 | Diaphorina citri | Citrus aurantifolia | El Roble, Cofradía de Morelos, Tecomán, Colima, MX. |
| [Hemiptera: Psyllidae] | 18°51’16.3” N 103°50’58.9” W | ||
| 329 | Diaphorina citri | Mexican lemon | El Roble, Cofradía de Morelos, Tecomán, Colima, MX. |
| [Hemiptera: Psyllidae] | 18°51’16.3” N 103°50’58.9” W | ||
| 330 | Diaphorina citri | Citrus aurantifolia | Tecuanillo, Tecomán, Colima, MX. |
| [Hemiptera: Psyllidae] | 18°49’00.1” N 103°52’58.8” W | ||
| 331 | Diaphorina citri | Citrus aurantifolia | Tecuanillo, Tecomán, Colima, MX. |
| [Hemiptera: Psyllidae] | 18°49’00.1” N 103°52’58.8” W | ||
| 332 | Diaphorina citri | Citrus aurantifolia | Cofradía de Morelos, Tecomán, Colima, MX. |
| [Hemiptera: Psyllidae] | 18°52’09.8” N 103°50’16.8” W | ||
| 333 | Diaphorina citri | Mexican lemon | El Roble, Cofradía de Morelos, Colima, MX. |
| [Hemiptera: Psyllidae] | 18° 52’ 4.26’’ N 103° 50’ 12.048’’ W | ||
| 335 | Diaphorina citri | Citrus aurantifolia | Cofradía de Morelos, Tecomán, Colima, MX. |
| [Hemiptera: Psyllidae] | 18°52’09.8” N 103°50’16.8” W | ||
| 337 | Diaphorina citri | Citrus aurantifolia | El Pandelo, Tecomán, Colima, MX. |
| [Hemiptera: Psyllidae] | 18°53’21.0” N 103°53’10.7” W | ||
| 338 | Diaphorina citri | Citrus latifolia | Tecuanillo, Tecomán, Colima, MX. |
| [Hemiptera: Psyllidae] | 18°49’00.1” N 103°52’58.8” W | ||
| 339 | Diaphorina citri | Citrus latifolia | Tecomán, Colima, MX. |
| [Hemiptera: Psyllidae] | 18°55’37.9” N 103°53’01.7” W | ||
| 341 | Diaphorina citri | Citrus latifolia | Tecomán, Colima, MX. |
| [Hemiptera: Psyllidae] | 18°55’37.9” N 103°53’01.7” W | ||
| 342 | Diaphorina citri | Citrus aurantifolia | Tecomán, Colima, MX. |
| [Hemiptera: Psyllidae] | 18°55’37.9” N 103°53’01.7” W | ||
| 345 | Diaphorina citri | Murraya paniculata | Tecomán, Colima, MX. |
| [Hemiptera: Psyllidae] | 18°55’37.9” N 103°53’01.7” W | ||
| 347 | Diaphorina citri | Citrus aurantifolia | Cofradía de Morelos, Tecomán, Colima, MX. |
| [Hemiptera: Psyllidae] | 18°52’09.8” N 103°50’16.8” W | ||
| 384 | Diaphorina citri | Mexican lemon | San José del Progreso, Tututepec, Oaxaca, MX. |
| [Hemiptera: Psyllidae] | 16° 13’ 33.577’’ N 96° 13’ 27.445’’ W | ||
| 386 | Diaphorina citri | Mexican lemon | San José del Progreso, Tututepec, Oaxaca, MX. |
| [Hemiptera: Psyllidae] | 16° 13’ 33.577’’ N 96° 13’ 27.445’’ W | ||
| 388 | Diaphorina citri | Mexican lemon | La Cañada, Tututepec Juquila, Oaxaca, MX. |
| [Hemiptera: Psyllidae] | 16° 0’ 0.047’’ N 96° 59’ 59.949’’ W | ||
| 392 | Diaphorina citri | Persian lemon | Tecomán, Colima, MX. |
| (IB-Hir-2) | [Hemiptera: Psyllidae] | 18°55’37.9” N 103°53’01.7” W |
All fungal isolates were obtained from the “Colección de Hongos Entomopatógenos” of the “Centro Nacional de Referencia de Control Biológico” (CHE-CNRCB; Mexico).
MO conservation method
Glass vials, 18 × 65 mm and of 12 mL capacity, were filled with 3 ml of SDA culture medium, supplemented with 1 % yeast extract (SDAY) [g/L: 40 dextrose, 10 peptone, 10 yeast extract, 15 agar], and sealed with Bakelite caps. The vials were sterilized at 121 °C for 15 min and then cooled down by tilting them at an angle of around 45°. Each vial was quadruplicatedly inoculated with mycelial segments and/ or synnema from each of the strains and incubated at 25 °C until synnema formation was observed, which took approximately 34 days. MO (density at 25 °C, 0.848 g/mL, and viscosity 83.5 SUS) was sterilized at 121 °C for 15 min, followed by a second sterilization at 180 °C for one hour after 24 to 48 h to eliminate the retained moisture (Smith et al. 2001). Under aseptic conditions, the cultures were covered with 8 ml of MO, leaving a one-centimeter gap above the culture. Finally, the vials were sealed with Parafilm® paper, labeled, and stored upright at a room temperature of 25 ± 2 °C (Montesinos-Matías et al. 2015).
Initial quality control tests and recovery of isolates stored for more than six years
The quality control tests involved recovering the fungus one week after preservation. To achieve this, all the oil was removed from one vial of each of the 20 isolates, and the excess was allowed to drain off. Using a sterile mycological loop, conidia and/or mycelium with synnemata were detached and placed in Petri dishes with ADSY culture medium. Observations were made under a stereoscopic microscope to verify the mycelial growth of each isolate after recovery. Since the fungus still retains a layer of oil, it can take up to two weeks to grow under these conditions. Therefore, it is recommended to take sections of the colonial growth and transfer them an oil-free medium.
For isolates stored for more than 6 years at 25 ± 2 °C, they were recovered in a similar way as the quality control in SDAY medium (Table 2). From this growth, 5 mm sections of mycelium were placed in SDAY. The media were sterilized for 15 min at 121 ºC. In all cases, they were seeded in triplicate and grown for 34 days at 25 ± 2 °C (Table 2). The characteristics were evaluated qualitatively, observing that the colonial growth and synnema production corresponded to the initial characteristics observed and inherent to the corresponding species.
Table 2 Species, acronym, years of conservation, recovered vials and presence of contaminants of the Hirsutella sp. isolates recovered from MO
| Species/Acronym CHE-CNRCB | Years of conservation | Vials with live fungus | Presence of contaminants |
|---|---|---|---|
| Hirsutella thompsonii | |||
| 327 | 6.33 | 2 of 3 | - |
| 327 | 6.33 | 3 of 3 | - |
| Hirsutella citriformis | |||
| 328 | 6.33 | 3 of 3 | - |
| 329 | 6.16 | 2 of 3 | 1 vial |
| 330 | 6.33 | 2 of 3 | - |
| 331 | 6.16 | 1 of 3 | 2 vial |
| 332 | 6.16 | 1 of 3 | - |
| 333 | NV** | 0 of 3 | - |
| 335 | 6.33 | 2 of 3 | 1 vial |
| 337 | 6.16 | 2 of 3 | - |
| 338 | 6.16 | 2 of 3 | - |
| 339 | 6.66 | 2 of 3 | - |
| 341 | 6.83 | 3 of 3 | - |
| 342 | 6.66 | 3 of 3 | - |
| 345 | 6.83 | 3 of 3 | - |
| 347 | 6.66 | 3 of 3 | - |
| 384 | 6.66 | 1 of 3 | - |
| 386 | 6.83 | 2 of 3 | - |
| 388 | 6.83 | 1 of 3 | - |
| 392 (IB-Hir-2*) | 6.66 | 2 of 3 | - |
*IB-Hir-2: acronym from the Biotechnology Institute at the Biological Sciences Faculty, Autonomous University of Nuevo León, Mexico (IBUANL)
**NV: not viable
Results
Figure 1 (a-e) show the colonial growth of some isolates CHE- CNRCB 335, 338, 339, 388 and 392 of H. citriformis grown in SDAY before to their preservation in MO. After six years of preservation in MO, viable growth was observed, and 19 isolates were recovered, except for isolate CHE-CNRCB 333 of H. citriformis (Tables 1, 2). In all fungi recovered using SDAY, initial growth was observed from the fifth to the sixth day. Isolates 327 (Figure 2a) and 377 of H. thompsonii (Figure 2b) were recovered in SDAY; in this culture medium, they exhibited irregular, raised, rough colonies, wavy margins, gray color, and no exudates were observed. The isolates of H. citriformis grown in SDAY displayed circular, flattened colonies with varying presence of striations, and gray to white color, along with different amounts of synnemata and exudates. These features were consistent with those observed in isolates 328, 329, 331, 332, 335, 339, 341, 384, 386, and 388 (Figure 2). However, isolate 392 (Figure 2s) exhibited rough type colonies. Isolates 342, 345, and 347 (Figure 2m, n, o) showed irregular, raised colonies with striations, gray-to-white color, and no synnemata or exudates. Isolate 345 (Figure 2n) demonstrated similar characteristics with rough-type colonies, which were distinct from other growths. In the same culture medium, isolates 330, 337, and 338 (Figure 2 e, i, j) displayed sinuous, rough colonies without exudates, but with a unique characteristic that made them similar to the original cultures: the growth of mucilaginous-looking colonies containing yeast-like bodies on the periphery of the colony. Isolate 339 also showed this type of growth although only in a small area of the colony (Figure 2s). Optical microscope observations at 40× magnification showed fungal hyphae and yeast-like bodies (Figure 3a, b).
Figure 1 Colonial growth of some isolates of Hirsutella citriformis grown in SDAY culture medium, at 34 days, 25 ± 2 °C, prior to their preservation in MO.
Figure 2 Strains of Hirsutella spp. recovered from MO and grown on SDAY culture medium, at 34 days, 25 ± 2 °C.

Figure 3 Colonial growth of the Hirsutella citriformis isolate CHE-CNRCB 332. a) mucilaginous-looking growth is observed in the initial stages of colonial development, and also on the periphery of mature culture. b) the microscopy (40×) allows to appreciate that the mucilage is made up of hyphae and yeast-like bodies (scale bar = 10 µm).
Discussion
The results of the study demonstrate that 17 isolates of H. citriformis and two of H. thompsonii (95 %) can be preserved in MO for more than six years at ambient temperature (25 ± 2 °C). According to Schönborn (1989), a minimum percentage of cultures preserved using this technique lose their viability after 5-6 years. In the present study, a similar result was observed with the CHE-CNRCB 333 isolate of H. citriformis, which was found to be non-viable.
Undoubtedly, procedures based on low temperatures (-70 °C, and -196 °C) are the best methods for the preservation of microorganisms. In a previous work by Ayala-Zermeño et al. (2017) the fungi H. citriformis and H. thompsonii were recovered viable in ultracold-freezing at -70 °C, and cryopreservation at -196 °C after two years of conservation with a DICE similarity coefficients from AFLP analysis show a value of 100 % for both species, as reported by López-Lastra et al. (2002) with H. thompsonii that was observed viable at 12 and 18 months in ultracold-freezing at -20 and -80 °C, respectively.
This study suggests the use of MO for the conservation of Hirsutella spp. as an alternative in laboratories that do not have the resources to implement ultracold-freezing at -70 °C, and cryopreservation at -196 °C, in addition to the limitations presented by H. citrifomis in other preservation methods, such as sterile distilled water (where the species survives for less than six months) (Ayala-Zermeño et al. 2017) or lyophilization (which is not suitable for fungi that are susceptible to this procedure) (Mier et al. 2005).
Several studies have reported on the viability of different fungal species using MO preservation. For instance, Smith and Onions (1983) reported 32 years (for example Verticillium theobromae, Torula sp., Penicillium sp., Aspergillus sp., and others) and Smith and Onions (1994), Rico et al. (2004), and Panizo et al. (2005) reported 47 (Candida parapsilosis and Candida tropicalis) and 48 years (Aspergillus niger). In the case of Hypocreales fungi, Little and Gordon (1967) reported 12 years of viability for Beauveria sp., and Mier et al. (2005) reported 1.5 years of viability for P. farinosus and V. lecanii. In entomopathogenic Entomophthorales fungi, Humber (2012) reported 1.5- and 0.25-years viability for Conidiobolus thromboides and Zoophthora radicans, respectively.
Buell (1947) reported that long-term preservation of fungi in MO can impact their development, conidial formation, and dimorphic process, due to microaerobiosis, nutrient loss, and toxic metabolite accumulation. Barnes (1984) noted that differences in species, temperature, and culture may affect a species’ ability to survive prolonged preservation using this method. Other factors, such as the timing of metabolic activity reduction, inoculum age, layer depth, and oil quality, can also affect preservation success (Fennell 1960, Pumpyanskaya 1964). To prevent deterioration and loss of viability (a cause of intraspecific variability), Smith and Onions (1994) recommend regularly transferring fungi preserved in this manner every one to two years. Although we did not conduct intermediate recoveries during the six-year preservation period, our samples were stored at a controlled temperature of 25 ± 2 °C. Most recovered colonies showed no apparent macroscopic alterations compared to some colonies of H. citriformis grown in SDAY prior to preservation in MO (Figure 1a-e), except for the CHE-CNRCB 345 isolate, which exhibited distinct morphological differences in growth on both culture media tested and differed significantly from inherent characteristics of the H. citriformis species. Panizo et al. (2005) report that 4.6 % of 241 species of filamentous fungi preserved in oil for 3 to 47 years displayed micro-morphological alterations. In contrast, Surja et al. (2020) found no morphological alterations or contamination after preserving Aspergillus sp., Trichophyton mentagrophytes, and Candida albicans fungi for six months, likely due to the short preservation period. However, the fungi did show reduced inhibition zones against antifungal agents. In studies carried out by Ayala-Zermeño et al. (2017) and (2023) tested the genetic stability of a strain of H. citriformis recovered at two and 7.2 years from the MO conservation method the DICE similarity coefficients from AFLP analysis show a values of 99.24 % and 98.07 % (standard deviation range from 0.57 to 3.51 %), respectively, which indicating a high genetic stability contrasted with the original isolate in this conservation method.
Concerning the H. citriformis isolates recovered in SDAY, some of them exhibited a phenotype with mucilaginous-looking colonies containing yeast-like bodies during the early stages of colony development (1-5 cm) and persisted for up to 34 days of growth (Figures 3a, b). Pérez-González et al. (2015b) also reported similar growth in H. citriformis isolates from Mexico; however, the authors noted that this phenotype is exclusively expressed under dark conditions, which is in contrasts to the present study where the isolates grew under both light and dark conditions.
Ex situ conservation is a crucial step in the utilization of microorganisms to preserve their inherent characteristics for prolonged periods. In the present study, H. citriformis and H. thompsonii fungi were conserved in oil, and most of the isolates were successfully recovered viable. However, it will be essential to evaluate the genetic integrity of these isolates over extended periods in future studies.











 nueva página del texto (beta)
nueva página del texto (beta)



